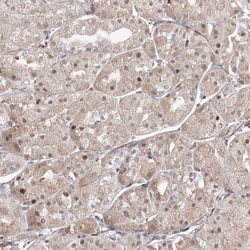
Invitrogen ARHGAP21 Polyclonal Antibody 100 &mu;L; Unconjugated:Antibodies,

missing translation for 'onlineSavingsMsg'
Learn More
Learn More
Invitrogen™ ARHGAP21 Polyclonal Antibody


Rabbit Polyclonal Antibody
Brand: Invitrogen™ PA557742
This item is not returnable.
View return policy
Description
Immunogen sequence: VPPCLTTSAP LIRRQLSHDH ESVGPPSLDA QPNSKTERSK SYDEGLDDYR EDAKLSFKHV SSLKGIKIAD SQKSSEDSGS RKDSSSEVFS DAAKEG Highest antigen sequence identity to the following orthologs: Mouse - 92%, Rat - 95%.
Functions as a GTPase-activating protein (GAP) for RHOA and CDC42. Downstream partner of ARF1 which may control Golgi apparatus structure and function. Also required for CTNNA1 recruitment to adherens junctions.
Specifications
| ARHGAP21 | |
| Polyclonal | |
| Unconjugated | |
| ARHGAP21 | |
| 5530401C11Rik; AA416458; ARHGAP10; ARHGAP21; Kiaa1424; Rho GTPase activating protein 21; rho GTPase-activating protein 10; Rho GTPase-activating protein 21; Rho-GTPase activating protein 10; rho-type GTPase-activating protein 21 | |
| Rabbit | |
| Antigen Affinity Chromatography | |
| RUO | |
| 57584 | |
| Store at 4°C short term. For long term storage, store at -20°C, avoiding freeze/thaw cycles. | |
| Liquid |
| Immunohistochemistry (Paraffin) | |
| 0.1 mg/mL | |
| PBS with 40% glycerol and 0.02% sodium azide; pH 7.2 | |
| Q5T5U3 | |
| ARHGAP21 | |
| Recombinant protein corresponding to Human ARHGAP21. Recombinant protein control fragment (Product #RP-97044). | |
| 100 μL | |
| Primary | |
| Human | |
| Antibody | |
| IgG |
Product Content Correction
Your input is important to us. Please complete this form to provide feedback related to the content on this product.
Product Title
Spot an opportunity for improvement?Share a Content Correction